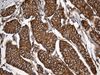

Alpha Fodrin (SPTAN1) Mouse Monoclonal Antibody [Clone ID: OTI9C10]
Frequently bought together (2)
Other products for "Alpha Fodrin"
Specifications
| Product Data | |
| Clone Name | OTI9C10 |
| Applications | IHC, WB |
| Recommended Dilution | WB 1:500~2000, IHC 1:2000 |
| Reactivities | Human, Mouse, Rat |
| Host | Mouse |
| Isotype | IgG1 |
| Clonality | Monoclonal |
| Immunogen | Human recombinant protein fragment corresponding to amino acids 1-147 of human SPTAN1 (NP_001123910) produced in E.coli. |
| Formulation | PBS (pH 7.3) containing 1% BSA, 50% glycerol and 0.02% sodium azide. |
| Concentration | 1 mg/ml |
| Purification | Purified from mouse ascites fluids or tissue culture supernatant by affinity chromatography (protein A/G) |
| Conjugation | Unconjugated |
| Storage | Store at -20°C as received. |
| Stability | Stable for 12 months from date of receipt. |
| Gene Name | spectrin alpha, non-erythrocytic 1 |
| Database Link | |
| Background | Spectrins are a family of filamentous cytoskeletal proteins that function as essential scaffold proteins that stabilize the plasma membrane and organize intracellular organelles. Spectrins are composed of alpha and beta dimers that associate to form tetramers linked in a head-to-head arrangement. This gene encodes an alpha spectrin that is specifically expressed in nonerythrocytic cells. The encoded protein has been implicated in other cellular functions including DNA repair and cell cycle regulation. Mutations in this gene are the cause of early infantile epileptic encephalopathy-5. Alternate splicing results in multiple transcript variants. [provided by RefSeq, Sep 2010] |
| Synonyms | DEE5; EIEE5; NEAS; SPTA2 |
| Reference Data | |
| Protein Families | Druggable Genome |
| Protein Pathways | Tight junction |
Documents
| Product Manuals |
| FAQs |
| SDS |
Resources
| Antibody Resources |
Other Versions
| SKU | Description | Size | Price |
|---|---|---|---|
| TA812019S | SPTAN1 mouse monoclonal antibody,clone OTI9C10 |
USD 159.00 |
{0} Product Review(s)
0 Product Review(s)
Submit review
Be the first one to submit a review
Product Citations
*Delivery time may vary from web posted schedule. Occasional delays may occur due to unforeseen
complexities in the preparation of your product. International customers may expect an additional 1-2 weeks
in shipping.






























































































































































































































































 Germany
Germany
 Japan
Japan
 United Kingdom
United Kingdom
 China
China